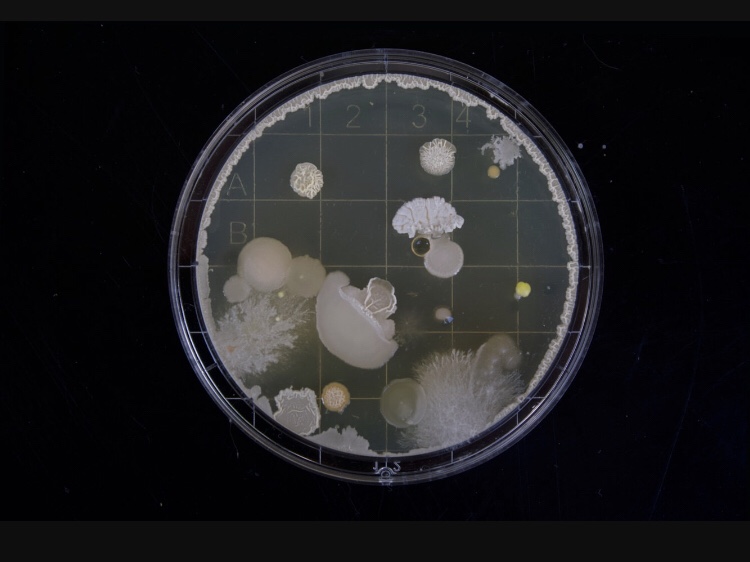

I am fascinated by science and nature having graduated with a BSci in Zoology and Physiology at University,
Nowadays when I’m asked to work with businesses I’m constantly seeing overlaps from nature that can be applied into business. Nature can provide a great lens from which to view a business problem or opportunity.
One example is Exponential growth in business driven by new technologies such as Artificial Intelligence (AI) and Quantum computing in particular.
Any poor University science undergrad will know the feeling of having to do afternoon practicals in the hot labs on a summer day while your Humanities friends spend their afternoons in their equivalent and ‘cool labs’ called beach bars.
I vividly remember a microbiology practical where I grew many different cultures of bacteria and remember being blown away by the speed at which the cells divided under the microscope.
I one looks to nature for examples of exponential growth. Bacteria are a perfect study subject.
Here are the main factors why bacteria grow so rapidly.
You may overlay these examples to emulate as you apply them to the use of new exponential technologies in your business and projects.
1. Simple Single Cell organisms.
2. Self reliant with Asexual reproduce for rapid growth.
3. Single Function – bacteria are programmed to grow by rapid cell mitosis.
4. Fast – bacteria grow fast as a built-in survival mechanism.
5. External Conditions need to be perfect
– neutral pH (company ‘culture’)
– Oxygen and Water (resources)
– Warm temperature (market conditions)
– Substrate on which to grow (with food, preferably protein)
How can you apply these features and conditions within your technology or projects for exponential growth like bacterium?
By WILL GREEN
B.Sci. UCT. Post Grad Marketing
Will Green has forged a successful career as an entrepreneur business leader over the past 18 year. He holds the degree of Bachelor of Science, with majors in Physiology & Zoology from the University of Cape Town. He also holds a Post Graduate Diploma in Marketing from the R&Y School of Marketing Management.
Will specialises in starting, running & leading new disruptive technology businesses. He has extensive experience in consumer behaviour and data. His passion is in exponential technologies that will help countries, organisations and individuals apply the power of abundant thinking and technologies to disrupt and democratise private and public industries.
Will has been intimately involved over the past 11 years advising various international companies (BSkyB, Yahoo, WWE, Manchester United, Sizmek, M4Jam, Vula Mobile) on various executive projects pertaining to expanding into Sub-Saharan African, including market assessment, commercial modelling, marketing, distribution strategies and execution plans.
He has deep experience dealing with and advising clients in the fields of expansion in emerging markets, revenue and profit optimization predominately across Emerging Markets such as Africa and subcontinental Asia.
Will has founded four companies in the Marketing, Media, Business Intelligence and Insurance spaces. He successfully exited his MarkTech company Sizmek Africa (Previously MediaMind Inc) so he could focus on his passion to solve meaningful societal problems with exponential technologies.
His most recent venture is Co.lab (Collaboration Lab) and their products FindBEN & PayBEN which are helping fund administrators find and pay over 5 million South Africans over $4 billion (R60 billion) in unpaid liabilities. To date these products have found over 90,000 beneficiaries and paid over $6 million (R90 million).
From 2015 to 2016 Will was Chairman of the Media Credit Coordinators (MCC), a non profit industry body that was responsible for managing a $200 million (R2.9 billion) trust for providing securities to most of the largest Media companies of Southern Africa including JSE listed Naspers, Times Media, Caxton and the SABC.
A founder member of Peter Diamandis’ Abundance Digital group of global thought leaders whom regularly connect, share and support each other in building their ventures in each respective market and fields of mastery.
Will is from time to time quoted in the press relating to the future of the consumer from a technology perspective. Recent fields of interest include Blockchain, AI and IoT. He has also written various articles for publications, and presented at technology conferences and is in the process of writing a book with his 80 year old father entitled ‘Founders and Fathers’.
Based in Cape Town but available Globally, with an emerging market perspective and abundant mindset in context to a global world in search of new markets and opportunities are what differentiates Will from other global leaders and entrepreneurs.
When not connected to the virtual technology world, he enjoys nothing more than unplugging in nature with his two children, one wife and a Norfolk Terrier called Harvey.